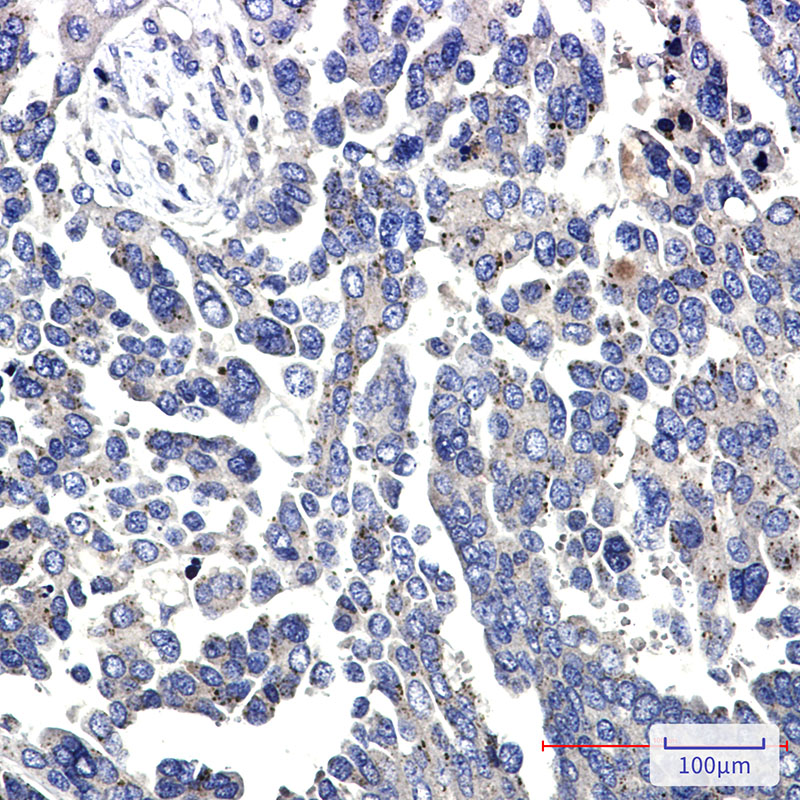

别名:PTK2; FAK; FAK1; Focal adhesion kinase 1; FADK 1; Focal adhesion kinase-related nonkinase; FRNK; Protein phosphatase 1 regulatory subunit 71; PPP1R71; Protein-tyrosine kinase 2; p125FAK; pp125FAK应用:WB,IHC
反应种属:Human
规格:50μl/100μl
| Description |
|---|
| This gene encodes a cytoplasmic protein tyrosine kinase which is found concentrated in the focal adhesions that form between cells growing in the presence of extracellular matrix constituents. The encoded protein is a member of the FAK subfamily of protein tyrosine kinases but lacks significant sequence similarity to kinases from other subfamilies. Activation of this gene may be an important early step in cell growth and intracellular signal transduction pathways triggered in response to certain neural peptides or to cell interactions with the extracellular matrix. |
| Specification | |
|---|---|
| Aliases | PTK2; FAK; FAK1; Focal adhesion kinase 1; FADK 1; Focal adhesion kinase-related nonkinase; FRNK; Protein phosphatase 1 regulatory subunit 71; PPP1R71; Protein-tyrosine kinase 2; p125FAK; pp125FAK |
| Entrez GeneID | 5747 |
| Swissprot | Q05397 |
| WB Predicted band size | Calculated MW: 119 kDa; Observed MW: 125 kDa |
| Host/Isotype | Rabbit IgG |
| Storage | Store at 4°C short term. Aliquot and store at -20°C long term. Avoid freeze/thaw cycles. |
| Species Reactivity | Human |
| Immunogen | A synthetic peptide of human FAK |
| Formulation | 50mM Tris-Glycine(pH 7.4), 0.15M NaCl, 40% Glycerol, 0.01% Sodium azide and 0.05% BSA |
| Application | |
|---|---|
| WB | 1/500-1/1000 |
| IHC | 1/50-1/100 |
![]() |
Western blot analysis of FAK in MCF-7, T47D, HCT116 lysates using FAK antibody. |
![]() |
Immunohistochemistry analysis of paraffin-embedded Human Cholangiocarcinoma using FAK antibody.High-pressure and temperature Sodium Citrate pH 6.0 was used for antigen retrieval. |
本公司的所有产品仅用于科学研究或者工业应用等非医疗目的,不可用于人类或动物的临床诊断或治疗,非药用,非食用。
暂无评论
本公司的所有产品仅用于科学研究或者工业应用等非医疗目的,不可用于人类或动物的临床诊断或治疗,非药用,非食用。
中文

发表回复